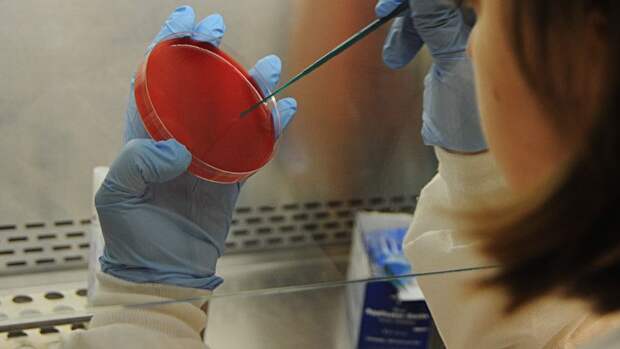

Посещение находящихся в Армении «биолабораторий» специалистами из России, США и Евросоюза было организовано в рамках сотрудничества с Москвой, Вашингтоном и Брюсселем, заявили в минздраве Армении, 22 апреля сообщило агентство Sputnik Армения. В министерстве подчеркнули, что в армянском законодательстве отсутствует термин «биолаборатории».
В стране функционируют лицензированные организации, которые оказывают лабораторно-диагностическую помощь и обслуживание. В них проводят диагностические исследования биологического материала бактериологическим, вирусологическим, паразитологическим, серологическим и молекулярно-генетическим методами, отметили в минздраве. По информации ведомства, часть этих организаций финансируются из госбюджета, а частные организации распоряжаются финансовыми средствами, действуя в рамках законодательства. «Основная цель лабораторий — обеспечение общественного здоровья с помощью диагностических исследований в отношении биологического фактора», — подчеркнули в министерстве. В ведомстве отметили, что для развития данной сферы в рамках сотрудничества с Россией, США, членами СНГ, ЕАЭС и ЕС и другими странами организовывались взаимные посещения лабораторий — как со стороны армянских, так и специалистов из указанных стран. Напомним, 19 апреля в Москве прошли переговоры президента России Владимира Путина и премьер-министра Армении Никола Пашиняна. В совместном заявлении, принятом по итогам переговоров, лидеры двух стран зафиксировали, что Армения и Россия не будут предоставлять третьим странам свои территории для деятельности в сфере биологической безопасности, направленной против интересов Москвы или Еревана. Ранее, 10 марта напротив посольства США в Ереване прошла акция протеста в связи с возможными разработками биологического оружия в армянских лабораториях, которые финансируются министерством обороны США. Международный эксперт по контролю зоонозных болезней и организации ветеринарного здравоохранения, лидер коалиции «Единое здоровье» Григор Григорян призвал Россию взять под контроль работу, проводившуюся в медико-биологических лабораториях бывших советских республик при финансировании Соединенных Штатов Америки.
Свежие комментарии